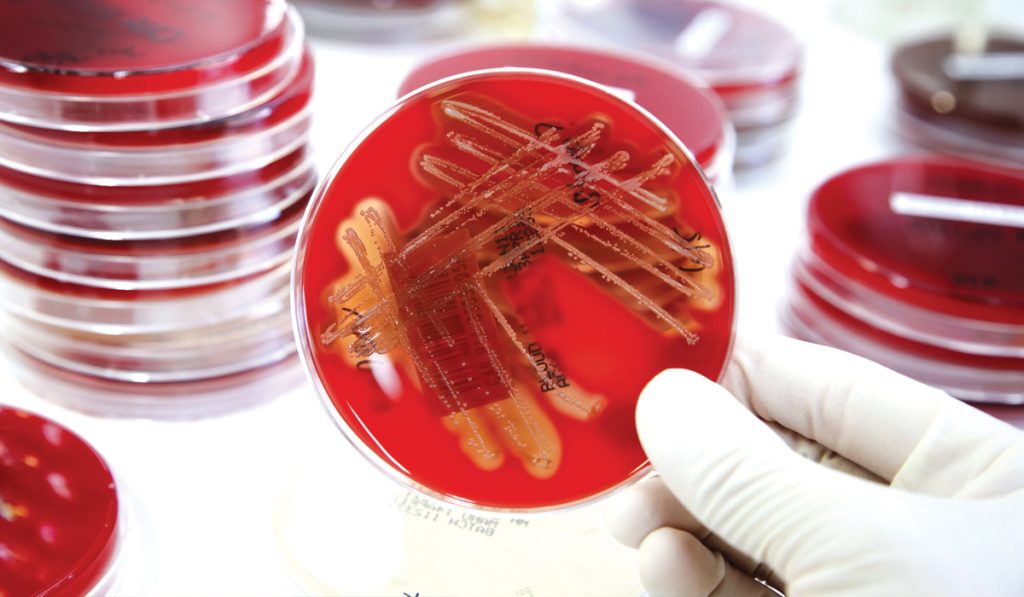

Before you take on spousal care
When caring for a spouse, approach with your eyes open, mind well-educated, and heart prepared for unexpected twists and turns. Here’s expert advice…
1. You committed. Caregiving for a spouse was a choice you made the day you took your wedding vows, says Peter Rosenberger, who, at age 61, has been caregiving for his spouse for almost four decades. His wife, Gracie, was seriously injured in a car accident just a few years before they married. She’s faced 86 surgeries and, ultimately, the amputation of her legs below the knee.
2. Create Plan B. “We are all one ankle sprain from this turning into a Greek tragedy,” says Rosenberger. Think about ahead about who’ll replace you if you aren’t up to the job. 3. Stay well. You can’t afford to be tired, stressed, or financially flailing “If I’m a train wreck, Gracie’s life becomes more dire.” 4. Avoid fear and guilt. “The goal isn’t to feel better but to be better “Healthy caregivers make better caregivers… I’m no good to her if I’m fat, broke, and miserable,” says Rosenberger.
Source: AARP

Blind travellers use other senses
For people with low vision, travel can be a feast for the other senses. Edith Lemay and Sébastien Pelletier learned that three of their four children were losing their vision because of retinitis pigmentosa (RP), a progressive, incurable retinal disease. It was 2018 and the “specialist” said, in the absence of a cure, the best thing for her to do was to build up her children’s storehouse of mental images by paging through illustrated encyclopedias together, “to look at the pictures of elephants and giraffes,” Lemay recalled, “so when they do go blind, at least they have an image of what it looks like.” But why look at pictures Lemay thought, when the real thing is more indelible?
The Montreal family had always wanted to travel the world, and now they had an urgent motivator. The film, Blink follows the family’s journey to 15 countries, hopscotching across a grid of Instagram-bright images: trekking at dawn in the Himalayas; camel rides in Egypt; whitewater rafting in the Amazon River Basin. National Geographic produced the film (The author wishes Lemay’s specialist had sought out blind people to learn about experiencing the world through our other four senses).
Source: Travel + Leisure
Canadian researchers find new class of antibiotics
The last time a new class of antibiotics reached the market was nearly three decades ago—but that could soon change, thanks to a discovery by researchers at McMaster University.
A team led by Professor Gerry Wright Michael G. DeGroote Institute for Infectious Disease Research has identified a strong candidate to challenge even some of the most drug-resistant bacteria on the planet: a new class of antibiotics called lariocidin. The discovery responds to a need for new antimicrobial medicines, as bacteria and other microorganisms evolve to withstand existing drugs. This phenomenon is called antimicrobial resistance—or AMR. Wright suggests that about 4.5 million die every year due to antibiotic-resistant infections, and it’s only getting worse.” The new molecule, a lasso peptide, holds great promise as an early drug lead because it attacks bacteria in a different way. Lariocidin binds directly to a bacterium’s protein synthesis machinery inhibiting its ability to grow and survive. Lariocidin is produced by a type of bacteria called Paenibacillus, which the researchers retrieved from a soil sample collected from a Hamilton backyard.
Source: McMaster Health Sciences
Images: CanStock. Vicki Ling – www.vickiling.com.